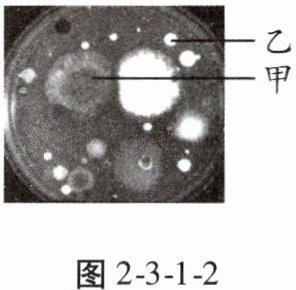

第76页
- 第1页
- 第2页
- 第3页
- 第4页
- 第5页
- 第6页
- 第7页
- 第8页
- 第9页
- 第10页
- 第11页
- 第12页
- 第13页
- 第14页
- 第15页
- 第16页
- 第17页
- 第18页
- 第19页
- 第20页
- 第21页
- 第22页
- 第23页
- 第24页
- 第25页
- 第26页
- 第27页
- 第28页
- 第29页
- 第30页
- 第31页
- 第32页
- 第33页
- 第34页
- 第35页
- 第36页
- 第37页
- 第38页
- 第39页
- 第40页
- 第41页
- 第42页
- 第43页
- 第44页
- 第45页
- 第46页
- 第47页
- 第48页
- 第49页
- 第50页
- 第51页
- 第52页
- 第53页
- 第54页
- 第55页
- 第56页
- 第57页
- 第58页
- 第59页
- 第60页
- 第61页
- 第62页
- 第63页
- 第64页
- 第65页
- 第66页
- 第67页
- 第68页
- 第69页
- 第70页
- 第71页
- 第72页
- 第73页
- 第74页
- 第75页
- 第76页
- 第77页
- 第78页
- 第79页
- 第80页
- 第81页
- 第82页
4. 培养细菌和真菌的一般步骤按先后顺序排列是( )
①高温灭菌 ②接种 ③配制含有营养物质的培养基 ④恒温培养
A.①②④③
B.③①②④
C.②①④③
D.①③②④
①高温灭菌 ②接种 ③配制含有营养物质的培养基 ④恒温培养
A.①②④③
B.③①②④
C.②①④③
D.①③②④
答案:
B
5. 在探究细菌和真菌的分布时,不合理的操作是( )
A.在实验正式实施前,不能打开培养皿
B.接种后,迅速盖好培养皿
C.接种后,需要进行恒温培养
D.接种后的培养皿和培养基要进行高温处理
A.在实验正式实施前,不能打开培养皿
B.接种后,迅速盖好培养皿
C.接种后,需要进行恒温培养
D.接种后的培养皿和培养基要进行高温处理
答案:
D 【解析】细菌、真菌在自然界广泛分布,几乎无处不在。因此,在实验正式实施前,不能打开培养皿,防止空气中的细菌和真菌落入培养皿中,A正确。在接种后,迅速盖好培养皿,可以避免空气中的细菌、真菌或孢子落入培养皿中,影响实验效果,B正确。细菌、真菌的生长需要适宜的温度,因此接种后需要进行恒温培养,C正确。接种后不能高温处理培养皿和培养基,会杀死已经接种的细菌或真菌,D错误。
6. 破伤风杆菌感染人体后会使人患破伤风。当伤口较深(如被铁钉扎伤)时容易得破伤风,而皮肤表面被划破一般不会得破伤风,说明破伤风杆菌的生存不需要( )
A.氧气
B.水分
C.有机物
D.适宜的温度
A.氧气
B.水分
C.有机物
D.适宜的温度
答案:
A
7. (2023·陕西中考)酸奶是利用乳酸菌将牛奶发酵后制成的。下列关于酸奶制作的叙述,正确的是( )
A.发酵时应处于密封条件下
B.牛奶煮沸后立即加入乳酸菌
C.发酵时应提供充足的光照
D.$0^{\circ}C$以下利于乳酸菌发酵
A.发酵时应处于密封条件下
B.牛奶煮沸后立即加入乳酸菌
C.发酵时应提供充足的光照
D.$0^{\circ}C$以下利于乳酸菌发酵
答案:
A
8. 下列环境中,细菌和真菌分布较多的是( )
A.流通的货币上
B.刚煮熟的食品中
C.腌制食品的盐水中
D.抽真空的罐头食品中
A.流通的货币上
B.刚煮熟的食品中
C.腌制食品的盐水中
D.抽真空的罐头食品中
答案:
A
9. 【真实情境】小丽用无菌棉棒擦拭妈妈的手机屏幕,然后在经过高温灭菌、冷却的培养基上涂抹。恒温培养 3 天后,肉眼观察到图 2 - 3 - 1 - 2 所示的现象:甲菌落较大且呈黑色絮状,乙菌落较小且表面光滑。以下说法正确的是( )

A.培养基不需要含水
B.甲是细菌菌落,乙是真菌菌落
C.一个菌落是由多种细菌或真菌繁殖形成的
D.手机未长菌落说明细菌、真菌的生存需要一定的条件
A.培养基不需要含水
B.甲是细菌菌落,乙是真菌菌落
C.一个菌落是由多种细菌或真菌繁殖形成的
D.手机未长菌落说明细菌、真菌的生存需要一定的条件
答案:
D
10. “使用公筷,筷筷有爱!”使用公筷真的有助于减少细菌的传播吗?研究人员就此开展了相关实验:
步骤一 研究人员在某餐厅点了六道菜,餐前对每道菜进行无菌采样。
步骤二 每道菜平均分成两份,测试人员进餐时一份使用公筷,另一份不使用公筷。餐后每份菜至少留下 25 克作为样本再次无菌采样。
步骤三 采集的样本都通过冷链运输(运输全程保持低温)到有关实验室,经过 48 小时的培养,统计每克样品中细菌的数量,结果如表 2 - 3 - 1 - 1 所示:

(1) 把每道菜平均分成两份,目的是____。
(2) 餐后每道菜中,细菌数量较多的都是____组。由此得出的结论是____。
(3) 提倡使用公筷,因为公筷进行了____处理。每道菜则相当于微生物培养过程中的____。
(4) 请结合检测数据,另提出一个合理且与生物学有关的问题:____?(合理即可)
步骤一 研究人员在某餐厅点了六道菜,餐前对每道菜进行无菌采样。
步骤二 每道菜平均分成两份,测试人员进餐时一份使用公筷,另一份不使用公筷。餐后每份菜至少留下 25 克作为样本再次无菌采样。
步骤三 采集的样本都通过冷链运输(运输全程保持低温)到有关实验室,经过 48 小时的培养,统计每克样品中细菌的数量,结果如表 2 - 3 - 1 - 1 所示:

(1) 把每道菜平均分成两份,目的是____。
(2) 餐后每道菜中,细菌数量较多的都是____组。由此得出的结论是____。
(3) 提倡使用公筷,因为公筷进行了____处理。每道菜则相当于微生物培养过程中的____。
(4) 请结合检测数据,另提出一个合理且与生物学有关的问题:____?(合理即可)
答案:
(1)设置对照实验
(2)非公筷 使用公筷有助于减少细菌的传播
(3)灭菌 培养基
(4)餐前凉菜中细菌数量明显多于热菜与温度有关吗(或餐后热菜中细菌数量增加的比例明显高于凉菜与温度有关吗)
(1)设置对照实验
(2)非公筷 使用公筷有助于减少细菌的传播
(3)灭菌 培养基
(4)餐前凉菜中细菌数量明显多于热菜与温度有关吗(或餐后热菜中细菌数量增加的比例明显高于凉菜与温度有关吗)
查看更多完整答案,请扫码查看


